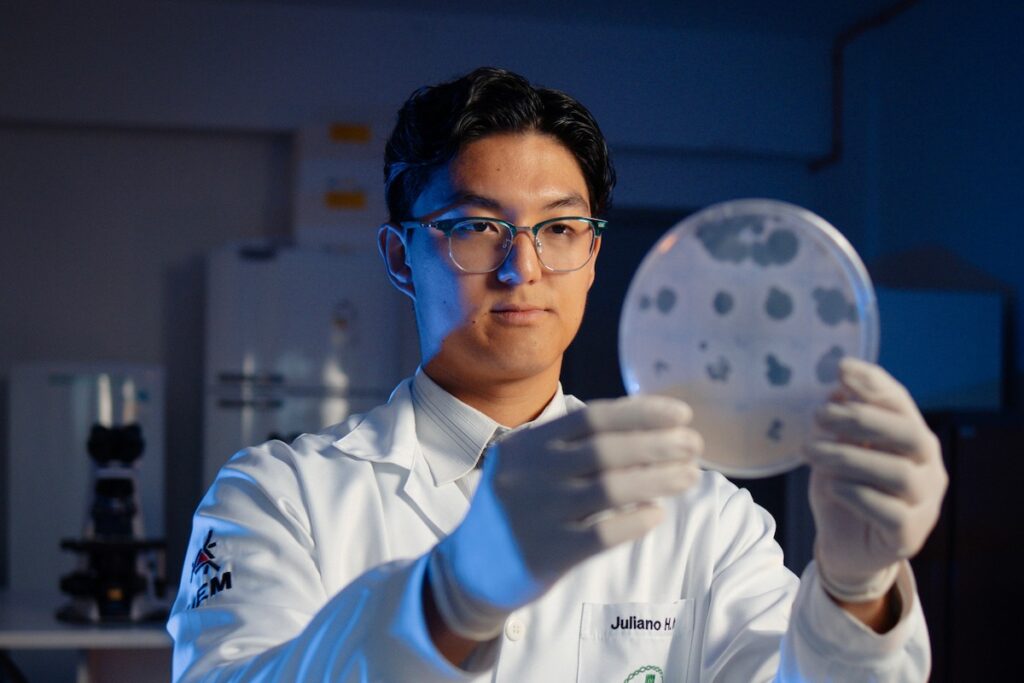
WhatsApp Image 2025-09-22 at 17.04.21
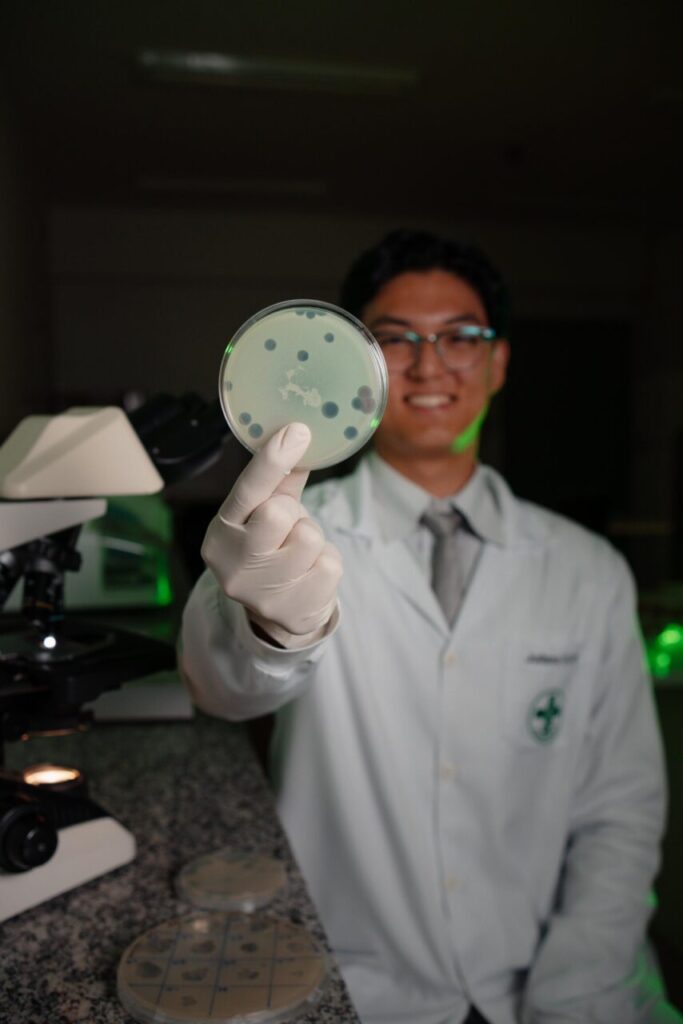
WhatsApp Image 2025-09-23 at 17.05.36

Jovem pesquisador de Maringá é um dos seis no mundo premiados em evento nos EUA
O maringaense Juliano Hiroyuki Ito, 22 anos, graduado em Biomedicina pela Universidade Estadual de Maringá (UEM), foi um dos seis jovens pesquisadores no mundo contemplados com o International Investigator Award, durante a seleção de trabalhos para o Congresso IDWeek 2025, um dos maiores eventos globais sobre doenças infecciosas. O congresso será realizado de 19 a 22 de outubro, em Atlanta (EUA), nos formatos presencial e virtual, e deve reunir cerca de 11 mil participantes.
- Acompanhe o GMC Online no Instagram
- Clique aqui e receba as nossas notícias pelo WhatsApp
- Entre no canal do GMC Online no Instagram
O prêmio inclui o Travel Award, auxílio financeiro de 1.500 dólares que cobre os custos de viagem e garante a participação presencial. O resumo submetido por Ito, intitulado “Impacto de medicamentos antituberculose na infectividade do micobacteriófago D29 em células hospedeiras de Mycobacterium smegmatis”, foi desenvolvido a partir de seu Trabalho de Conclusão de Curso (TCC).
A pesquisa explora o uso de bacteriófagos, vírus que infectam bactérias, como alternativa terapêutica diante do crescente problema da resistência antimicrobiana. A ideia surgiu após leituras científicas e a descoberta de uma amostra viral disponível no laboratório de Patologia Médica da UEM, que já atua fortemente em estudos sobre tuberculose, mas com foco em produtos naturais.
“Eu achei fascinante utilizar um vírus para combater uma doença. Como não havia técnicas padronizadas na UEM sobre bacteriófagos, precisei me esforçar bastante para desenvolver o trabalho, contando apenas com apoio teórico dos professores”, contou Ito em entrevista ao Portal GMC Online.
Após a defesa do TCC e os elogios recebidos pela banca, Ito decidiu transformar o estudo em resumo científico e submetê-lo ao congresso internacional. “Foi uma oportunidade única. Não consegui publicar como artigo completo, mas o trabalho foi bom o suficiente para ser reconhecido fora do Brasil”, afirmou.

A IDWeek é organizada por um consórcio de sociedades médicas norte-americanas, incluindo a Sociedade Americana de Doenças Infecciosas e a Sociedade Americana de Epidemiologia, sendo referência mundial na área. Em média, mais de três mil resumos são aceitos a cada edição, mas apenas alguns são selecionados para apresentações orais — entre eles o trabalho de Ito.
Essa será a primeira viagem internacional do pesquisador, que já planeja os próximos passos acadêmicos: “Meu objetivo é ingressar em um PhD no exterior aproveitando a experiência em pesquisa adquirida na iniciação científica e no TCC”, revelou.
Em Atlanta, Ito terá a chance de apresentar oralmente seu estudo, em inglês, para especialistas do mundo todo. Ansioso, ele diz esperar que a participação abra portas para novas oportunidades:
“É um sonho realizado. Quero representar bem o Brasil e, quem sabe, chamar a atenção de algum professor para me recrutar no futuro”.
